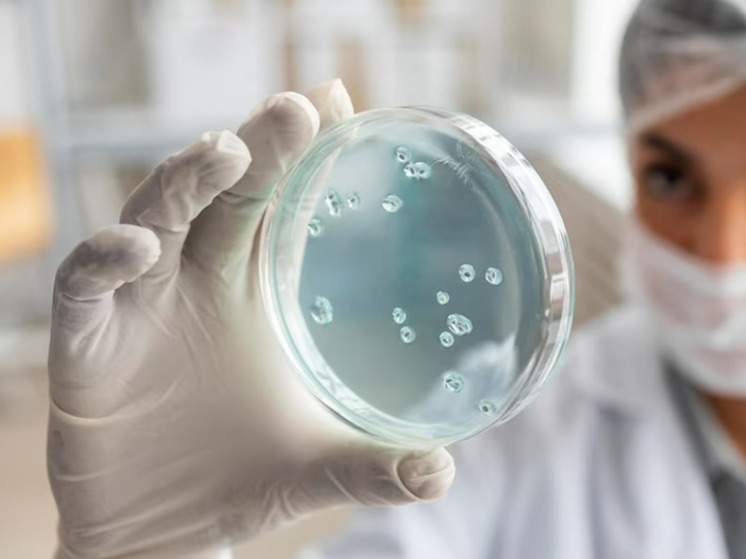
Вирус кори мутировал: врач предупредил всех, кто в группе риска

«Дочки привезли заразу из лагеря» Поделиться
Москвичка Наталья в соцсетях написала, что их семья на карантине — у дочери на днях обнаружилась корь. Привезли из детского лагеря. Причём заболели три девочки, кто жил в одной палатке, но палаток в лесу было много, обедали тоже все вместе, тусили, — и что там развезли из огромного детского лагеря остальные в свои города и веси, никто не знает.
Тут же в откликах стали комментировать другие пострадавшие: и у нас корь, и у нас.
«Инфекционист приходил пару месяцев назад — в нашем доме корь в Новой Москве. Все привиты».
«Знакомая недавно болела в Индии, температура 40 неделю, врачи ничего не могли сделать, так и сказали: или умрет или выживет, у взрослых сложнее проходит».
«Моя дочь тоже привита, переболела в начале лета. Сыпь прошла на третий день. Врачи консилиум собирали, корь не ставили, но держали дома три недели. Никто больше не заболел».
«Мы были в первой волне. В итоге уехали с мигалками. Лежали в боксе с ещё одним малышом и его мамой. Корм заносили с улицы и т д. У родительниц только день на третий спросили: есть ли прививки? Потом сказали, что прививки от кори работают 50/50».
Неужели сбываются самые страшные страшилки начала этого года, когда россиянам объявили, что на нас надвигается ещё и корь. И посоветовали всем срочно прививаться. А тем, кто был привит, – на всякий случай привиться ещё раз.
«У меня дочь как раз и была привита, как положено, — рассказала «МК» Наталья, мама заболевшей 13-летней Тони. — И подружки ее, которые тоже заразились, привиты, врачи, что приехали на вызов, сказали, что прививки часто не срабатывают».
Правда, медики пообещали, что, если прививка имеется, то, скорее всего, будет лёгкое течение.
«Температура сорок, бредит, плачет очень сильно и все время меня зовёт, и так продолжается уже несколько дней, — продолжает Наталья. — Если это «лёгкое» течение, то что тогда считать тяжёлым?»
В феврале этого года главный санитарный врач РФ пообещал россиянам корь и постановил, что в период с 3 апреля по 31 декабря 2023 года вакцинироваться от этой инфекции должны все, кто вакцинировался давно или не имеет сведений о наличии этой прививки, прежде всего детское население, а также взрослые, ведущий «кочевой или полукочевой образ жизни», трудовые мигранты и вынужденные переселенцы. Процесс этот назвали «подчищающая иммунизация». В группу тех, кому это сделать желательно, вошли однократно привитые против кори дети старше 6 лет и взрослые до 35 лет, отдельные категории — до 55 лет.
При чтении документа РПН складывается впечатление, что иначе наступят кранты. Тогда как сами цифры заболевших за последние несколько лет удручающего впечатления не производят. Так 2021 году в России был зарегистрирован только 1 подтверждённый случай заболевания кори. В 2022 году — 101 заболевание.
Вспышки имеют цикличный подъем, и примерно через каждые четыре года наблюдается всплеск заболеваемости. Предыдущий подъем наблюдался в 2019 году, тогда в мире зарегистрировали 870 тысяч случаев инфицирования. Видимо, 2023 год пришёлся на очередной пик. И с этим ничего не сделаешь!
Смертность от кори на сегодня, по данным ВОЗ, составляет порядка 0,2% от числа заболевших.
По сравнению с борьбой с корью, борьба с дифтерией выглядит ещё более бескомпромиссной: другим февральским постановлением Главного государственного санитарного врача РФ 95% граждан было предписано вакцинировать от дифтерии до 31 декабря 2023 года.
В документах прямо указывалось, что представители региональных министерств здравоохранения должны обеспечить тщательное рассмотрение любых медицинских отводов от вакцинации. И по максимуму переубеждать тех, кто не был согласен на эту процедуру. Действовать не битьем, как в эпоху коронавируса, но настойчивыми уговорами. Сколько, кстати, уже сходили в процедурный кабинет за четыре месяца?
Отчет о реализации «подчищающей иммунизации» от кори и дифтерии на местах необходимо было предоставлять в Роспотребнадзор каждую неделю с момента начала кампании и до ее завершения. Прививочная кампания для регионов получалась весьма недешевой, особенно по нынешним временам.
Но самое интересное, что как только людей начали прививать, так сразу кривая заболеваемости той же корью пошла вверх.
О том, что диагностируются все новые и новые случаи стали говорить повсеместно. За минувшие полгода, по разным данным, зарегистрировано несколько тысяч заболевших.
Самые резонансные случаи, о которых писали СМИ: РГУ нефти и газа имени Губкина в Москве закрыли на карантин в апреле из-за заболевших студентов, в Братске гражданка устраивала спиритические сеансы, после чего заболела.
В Татарстане 28 июля сообщили о том, что с начала года на территории республики выявили 83 случая заражения, почти половина из них приходится на иностранных граждан. 16 июля вспышку кори выявили в Пензенской области — по данным на 25 июля, число заболевших составило 78 человек.
Много это или мало? Топы по заболеваемости — основные мегаполисы, Татарстан, Пермский край.
Но опять же, нигде количество одновременно заболевших не пересекает двухзначную цифру.
Почему тогда вообще считается, что это рост и это ведёт к эпидемии?
Если охват привитых от кори детей в нашей стране, по словам главы РПН Анны Поповой, составляет примерно 97%, и этого достаточно, чтобы иметь контроль над заболеваемостью. И даже коронавирусная пандемия, во время которой многие семьи переносили плановые прививки, не слишком повлияла на эту цифру.
Сколько «подчищающе» привились за последние месяцы? Таких данных пока нет. Известно только, что в апреле за прививками сходили порядка 500 тысяч человек.
Сейчас эта цифра, вероятно, уже гораздо больше. Тем более, что в некоторых регионах даже наблюдается дефицит вакцин. Все закончились? Из-за наплыва желающих, или в результате санкций перестали поставляться из-за границы?
— Как мне сказали в одной из частных клиник, вакцины корь-краснуха-паротит нет нигде, а также нет у поставщиков, и до конца года именно этой вакцины не будет. Большинство родителей либо ожидают, либо ищут по городу, — написала в редакцию одного из федеральных изданий жительница Новосибирска.
Москвичка Наталья говорит, что страшно испугалась, когда дочка заболела, но до последнего была уверена, что это не корь. «Этого не может быть, потому что этого не может быть никогда. Нас так учили. Привит, – следовательно, защищён».
У подружки ее дочери, заболевшей первой, заподозрили менингит, так как начались сильные головные боли.
«Что очень сильно напугало, ноги не разгибались. Судороги. Сыпь проявилась в формате 3D. Врачи сказали, что все индивидуально».
Сама Наталья не помнит, болела она или нет. Но прививку точно делала в детском возрасте, то есть 30+ лет назад. «Доктор не сказал срочно бежать и экстренно прививаться, как я прочитала в интернете, в течении 72 часов после контакта с больным. Я говорю: «Где тесты? Где анализы? Вы откуда уверены, что это именно корь?»
«Не волнуйтесь, мамаша, доктор сказал корь, значит, корь, или вы хотите, чтоб у ребёнка воооот такой иглой пункцию из позвоночника просто так взяли?», — передаёт в лицах Наталья.
В итоге им рекомендовали измерять температуру, много пить и лечиться симптоматически. И ничего не бояться. «Вообще я предлагала госпитализировать нас всех, но мне ответили, что это не нужно, и чтобы я не нервничала». Главный вопрос, который и сейчас мучает женщину, почему все-таки заболели девочки? И в чем тогда смысл новой массовой прививочной кампании?
Мы попросили высказаться на эту тему Владислава Шафалинова, профессора, доктор медицинских наук:
— Почему заболевают привитые дети? Значит ли это, что штамм кори как-то изменился за последние годы и старая прививка не вырабатывает иммунитет?
— Да, такие данные есть. Исследования проводились в США и в Китае. О том, что именно вакцинированные заболевают, и связывают это с тем, что вирус кори мутирует.
— Это как-то может быть связано с тем, что вирус обходит поствакцинальный иммунитет, и поэтому прививка не помогает?
— Я не могу ответить на этот вопрос. Думаю, что тот, кто это сделает, получит Нобелевскую премию. Сейчас периодически появляется информация в СМИ, что идёт рост заболеваемости, но лично в моем окружении никто не заболел.
— Я бы никогда не стала писать на такую тему по команде. Но факт есть факт — у знакомой дети заболели, в чатах много таких сведений от реальных людей, чьи дети болели или болеют. Болезнь заразная, как известно, ее могут легко распространить дальше.
— Я думаю, что это связано не с конкретной вспышкой, а с тем, что хотят заставить всех прививаться. Вот и все. Возможно, есть некое распоряжение разгонять волну для этого.
— Но, как выясняется, прививка не защитила никого из моих личных знакомых. Так что здесь больше антиреклама получается. Даже если это единичные случаи, то корь очень контагиозное заболевание, говорят, разносится даже по вентиляционным трубам. Что нужно делать, чтобы не заболеть?
— Есть научные данные о том, что хронический дефицит витамина А является триггером к заболеванию кори у детей. Но никаких рекомендаций я не даю, это к врачам, которые непосредственно консультируют пациентов.
— А что делать совершеннолетним? Кто в группе риска? Утверждается, что особенно опасен этот вирус как раз у взрослых людей. Вот я, к примеру, не привитая и корью не болела.
— Откуда знаете, что не болели?
— Мама говорила. Я, как и многие в моем детстве, общалась с больными детьми в детском саду, потом всех закрыли на карантин, но я, по словам родителей, так и не переболела. Думаю, это не какая-то уникальная ситуация. В таком подвешенном положении могут оказаться многие.
— Но вы не можете быть уверены, что не болели, тем более, если были контакты. Существует инаппаратная форма течения, когда человек переболевает, но внешне это никак не проявляется, а в крови нарастает титр специфических антител. Поймите, до появления прививок это была исключительно детская инфекция. Единожды заболев, у ребёнка формировался пожизненный иммунитет. Сегодня в эпоху прививок, которые не дают такого же стойкого иммунитета, болеют и непереболевшие взрослые. И да, более тяжело, чем дети. Поэтому корью лучше переболеть в детстве. Как это и было раньше.
— Может, тем, кто сомневается, заодно проверить антитела? Чтобы убедиться — болели или нет?
— После перенесённой инфекции антитела, как правило больше пяти лет в организме не живут. Они исчезают раньше или позже. Так что определение антител к кори для оценки наличия иммунитета может оказаться бесполезным. Но Т-клеточный (приобретенный после заболевания долговременный – авт.) иммунитет формируется у переболевших корью пожизненно. Тогда при новом соприкосновении человека с вирусом кори организм снова выработает антитела.









































